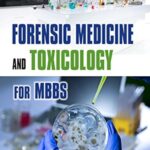
Forensic Medicine And Toxicology For Mbbs

Textbook Of Community Medicine Preventive And Social Medicine 8Ed (Pb 2024)
₹1,495.00 Original price was: ₹1,495.00.₹1,040.00Current price is: ₹1,040.00.
Forensic Medicine And Toxicology For Mbbs
₹995.00 Original price was: ₹995.00.₹899.00Current price is: ₹899.00.
COMMUNITY MEDICINE BUSTER (AS PER THE COMPETENCY-BASED MEDICAL EDUCATION CURRICULUM (NMC)
₹1,375.00 Original price was: ₹1,375.00.₹1,135.00Current price is: ₹1,135.00.
Description
- Publisher : Jaypee Brothers Medical Publishers Pvt. Ltd.; Fifth Edition (1 September 2024); Jaypee Brothers Medical Publishers Pvt. Ltd.4838/24, Ansari Road, Daryaganj, New Delhi – 110 002, INDIA
- Language : English
- Paperback : 800 pages
- ISBN-10 : 9356969949
- ISBN-13 : 978-9356969940
- Reading age : 18 years and up
- Item Weight : 1 kg 380 g
- Dimensions : 2.5 x 21 x 26.7 cm
- Country of Origin : India
- Importer : Jaypee Brothers Medical Publishers Pvt. Ltd.
- Packer : Jaypee Brothers Medical Publishers Pvt. Ltd. 4838/24, Ansari Road, Daryaganj, New Delhi – 110 002, INDIA
- Generic Name : Books
Reviews (0)
Be the first to review “COMMUNITY MEDICINE BUSTER (AS PER THE COMPETENCY-BASED MEDICAL EDUCATION CURRICULUM (NMC)” Cancel reply
Shipping and Delivery
We dispatch your books within 24 hours of order confirmation. Every order is carefully checked for quality, damages, and completeness before being securely packed for safe transit.
Once your order is shipped, your books will usually reach you within 3 to 4 working days, depending on your location.
If you ever need your tracking details or any assistance, simply reach out to us through the WhatsApp button on your screen, and our team will be happy to help.
Oh, and one last thing…
Thank you for choosing MittalMedBooks — your trust truly means everything to us!












Reviews
There are no reviews yet.